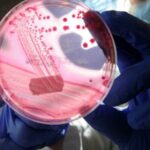

(Adnkronos) – 'Scherzetto' di Halloween: aumenti da brividi nel 2024 per festeggiare la ricorrenza più inquietante dell’anno. Tra maschere, trucchi e decorazioni, secondo l'Osservatorio Nazionale Federconsumatori i costi per feste e travestimenti quest'anno costeranno mediamente un +9,3% rispetto al 2023. A partire dalla maschera. Dai tradizionali costumi da vampiri, zombie, streghe, scheletri, a quelli più di tendenza ispirati a cinema e serie tv (Hannibal lecter, It-girl, Joker o le atmosfere dark dei film di Tim Burton), per l’acquisto di un costume 'da brividi' si spendono dai 55,99 euro per un bambino a 64,99 euro per un adulto: rispettivamente il +6% e il +11% rispetto al 2023. Meglio il noleggio? In questo caso sono stati rilevati i prezzi delle maschere a Milano (69,95 euro), Roma (70 euro) e Napoli (48 euro), con aumenti di prezzo rispetto al 2023 dal +8% al +10%. Una maschera di Halloween non può dirsi completa senza un make-up adeguato: in base al formato del kit, i trucchi hanno un costo che va dai 13 ai 28,18 euro, con un aumento tra il 4 e il 6%. Per i bambini che nella notte di Halloween bussano alle nostre porte bisogna, come noto, dotarsi di caramelle (costo medio 3,65 euro per 200 grammi) e cioccolatini (costo medio 4,50 euro per 250 grammi) da distribuire. Nei supermercati e nelle pasticcerie si trovano in vendita invitanti biscotti decorati (costo medio 5,15 euro per 200 grammi) che riproducono i simboli della festività, come zucche, fantasmi, cappelli di strega e pipistrelli, o mele stregate (dal costo di 7 euro) ricoperte di glassa di zucchero. Secondo l'Osservatorio Federconsumatori, nel 2024 i biscotti decorati segnano un +12% del prezzo rispetto al 2023, i cioccolatini +11%, le caramelle +18%.
Cene e feste a tema. Per una festa privata in un locale bisogna considerare un costo medio di circa 380 euro per l’affitto della sala, a cui si aggiungono 20 euro a persona per un buffet caldo e 137 euro di diritti Siae. Aggiungendo fotografo, animatore e truccatore bisognerà sborsare rispettivamente 165, 108 e 98 euro. Per una cena in uno dei tanti ristoranti che propongono allestimento e menù a tema, il costo medio è di 51,33 euro con un aumento del 9,6% rispetto al 2023. Secondo l'Osservatorio, tra Milano, Roma e Napoli le cene a tema più 'salate' sono quelle proposte dai locali milanesi (62 euro, +13%), a Roma la cifra si attesta sui 55 euro (+10%), più contenuta a Napoli con 37 euro (+6%). —[email protected] (Web Info)
Halloween, aumenti da brividi: +9,3% della spesa nel 2024

Nessun commento
Nessun commento